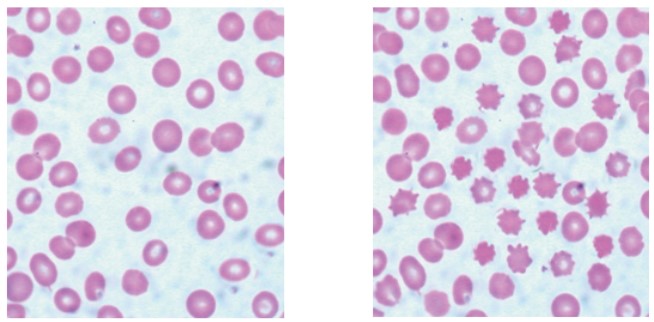

Question 1
Onion (Allium cepa) epidermis was placed in pure water and observed with a light microscope using high magnification.

What would happen to these cells if they were transferred to a hypertonic solution?
A. Cells would gain mass.
B. Cells would take in water by osmosis and swell.
C. Cells would burst open, releasing their content.
D. Cell membranes would detach from walls at some points.
Easy
Mark as Complete
Mark Scheme
Question 2
In an experiment on osmosis, red blood cells were immersed in a salt solution for two hours. The micrographs show the appearance of these cells before and after immersion in the salt solution.
before immersion after immersion
 What explains the observed changes?
What explains the observed changes?
A. The salt solution was hypertonic and entered the red blood cells.
B. The salt solution was hypotonic and disrupted the membranes of the red blood cells.
C. The salt solution was hypertonic and water moved into it from the red blood cells.
D. The salt solution was hypotonic and mineral salts were lost from the red blood cells.
Easy
Mark as Complete
Mark Scheme
Question 3
A human organ is being prepared for transplant. In what type of solution must it be bathed?
A. A hypertonic solution
B. A hypotonic solution
C. Pure water containing no solutes
D. A solution with the same osmolarity as the organ tissue
Easy
Mark as Complete
Mark Scheme
Question 4
The salt concentration inside an animal cell is`1.8`%. The salt concentration in the surrounding medium becomes 5 %. What will be the likely response?
A. The cell will gain water from the medium.
B. The cell will lose salt to the medium.
C. The cell will remain unchanged.
D. The cell will shrink from loss of water.
Easy
Mark as Complete
Mark Scheme
Question 5
What is osmosis?
A. The movement of water through a membrane from a low to a high solute concentration.
B. The movement of solutes through a membrane from a high to a low water concentration.
C. The movement of water through a membrane from a high to a low solute concentration.
D. The movement of solutes through a membrane from a low to a high water concentration.
Easy
Mark as Complete
Mark Scheme
Question 6
Two plant cells are shown as they appear in different solutions X and Y.

What happens to water and pressure potential inside the cell if it is moved from solution X to solution Y? 
Medium
Mark as Complete
Mark Scheme
Question 7
Which process(es) occur(s) by osmosis?
I. Uptake of water by cells in the wall of the intestine
II. Loss of water from a plant cell in a hypertonic environment
III. Evaporation of water from sweat on the skin surface
A. I only
B. I and II only
C. II and III only
D. I, II and III
Easy
Mark as Complete
Mark Scheme
Question 8
The images show samples of red blood cells that were placed in different concentrations of salt solutions.

Which process explains the observations shown in the images?
A. Active transport
B.Exocytosis
C. Facilitated diffusion
D. Osmosis
Medium
Mark as Complete
Mark Scheme
Question 9
Outline the effects of putting plant tissue in a hypertonic solution. [4]
Medium
Mark as Complete
Mark Scheme
Question 10
Explain the process of osmosis with reference to its effects on plant cells. [7]
Hard
Mark as Complete
Mark Scheme
Question 11
Explain how water is moved from roots to leaves in terrestrial plants. [8]
Hard
Mark as Complete
Mark Scheme
Question 1
Onion (Allium cepa) epidermis was placed in pure water and observed with a light microscope using high magnification.

What would happen to these cells if they were transferred to a hypertonic solution?
A. Cells would gain mass.
B. Cells would take in water by osmosis and swell.
C. Cells would burst open, releasing their content.
D. Cell membranes would detach from walls at some points.
Answer: D
A. Incorrect: This would happen only in a hypotonic solution, where water moves into the cells. But since the question states the cells are in a hypertonic solution, water moves out, so the cells would lose mass, not gain it.
B. Incorrect: This happens in a hypotonic solution, not in a hypertonic one. In a hypertonic environment, the direction of osmosis is outward, so the cells shrink rather than swell.
C. Incorrect: This might occur in animal cells (which lack a cell wall) if placed in pure water. However, plant cells have a strong cell wall that prevents them from bursting. In a hypertonic solution, the opposite happens - they lose water and shrink, not burst.
D. Correct: In a hypertonic solution, the water potential outside the cell is lower than inside the cell. Therefore, water leaves the cytoplasm and vacuole through osmosis. As water leaves, the cytoplasm and vacuole shrink, and the plasma membrane pulls away from the rigid cell wall - this is known as plasmolysis. Under a microscope, you would see gaps forming between the cell wall and the cell membrane, particularly near the corners or edges exactly what option D describes. So, this option correctly describes plasmolysis, which occurs when plant cells are placed in a hypertonic environment.
Question 2
In an experiment on osmosis, red blood cells were immersed in a salt solution for two hours. The micrographs show the appearance of these cells before and after immersion in the salt solution.
before immersion after immersion
 What explains the observed changes?
What explains the observed changes?
A. The salt solution was hypertonic and entered the red blood cells.
B. The salt solution was hypotonic and disrupted the membranes of the red blood cells.
C. The salt solution was hypertonic and water moved into it from the red blood cells.
D. The salt solution was hypotonic and mineral salts were lost from the red blood cells.
Answer: C
A. Incorrect: In a hypertonic solution, water leaves the cells - solutes (like salt) do not enter the cells because they cannot easily cross the cell membrane. If solutes entered, the cells would swell, not shrink. Therefore, this option contradicts the observed shrinkage.
B. Incorrect: A hypotonic solution has a lower solute concentration (higher water potential) than the cytoplasm. In this case, water would enter the red blood cells, causing them to swell and possibly burst (lyse). But the micrograph shows shrunken, spiky cells, not swollen ones.
C. Correct: A hypertonic solution has a higher solute concentration (and therefore lower water potential) than the cytoplasm of the red blood cells. When red blood cells are placed in such a solution, water moves out of the cells by osmosis - from an area of higher water potential (inside the cells) to an area of lower water potential (the salt solution). As water leaves, the cells shrink and become crenated (their membranes wrinkle and form spiky edges). This is exactly what is observed in the after immersion image.
D. Incorrect: This option is wrong for two reasons. First, the solution was hypertonic, not hypotonic. Second, osmosis involves the movement of water, not mineral salts - ions cannot freely move across the red blood cell membrane without transport proteins. Therefore, this explanation does not fit the observed change.
Question 3
A human organ is being prepared for transplant. In what type of solution must it be bathed?
A. A hypertonic solution
B. A hypotonic solution
C. Pure water containing no solutes
D. A solution with the same osmolarity as the organ tissue
Answer: D
A. Incorrect: A hypertonic solution has a higher solute concentration (and therefore lower water potential) than the organ’s cells. Water would move out of the cells by osmosis, causing them to shrink (crenate). This would damage or kill the cells, making the organ unsuitable for transplant.
B. Incorrect: A hypotonic solution has a lower solute concentration (higher water potential) than the organ’s cells. Water would move into the cells by osmosis, causing them to swell and potentially burst (lysis). This also damages the tissue and makes the organ nonfunctional.
C. Incorrect: Pure water is the most extreme hypotonic solution possible. It has no solutes, so water would rapidly enter the cells, leading to severe swelling and bursting of cell membranes. This would destroy the organ tissue very quickly.
D. Correct: Osmolarity refers to the total concentration of solute particles in a solution. For a transplanted organ, it’s essential that the cells in the tissue do not gain or lose water during storage or transportation. To achieve this, the organ must be bathed in an isotonic solution - a solution that has the same osmolarity (solute concentration) as the cells and body fluids of the organ. In an isotonic environment: the water potential inside and outside the cells is equal; there is no net movement of water into or out of the cells; this maintains the normal shape, size, and function of the cells, preventing damage before transplantation. Therefore, this option is correct because it ensures the organ cells remain stable and viable for transplantation.
Question 4
The salt concentration inside an animal cell is`1.8`%. The salt concentration in the surrounding medium becomes 5 %. What will be the likely response?
A. The cell will gain water from the medium.
B. The cell will lose salt to the medium.
C. The cell will remain unchanged.
D. The cell will shrink from loss of water.
Answer: D
A. Incorrect: This would only occur if the external medium were hypotonic (lower salt concentration than the cell). However, the medium here has more salt (`5%`), so water moves out, not in. Therefore, the cell loses water rather than gains it.
B. Incorrect: Osmosis involves movement of water, not salt ions. The cell membrane is selectively permeable - water moves freely, but salts (ions) typically do not diffuse out easily without specific transport proteins. The main change here is water loss, not salt loss, so this is incorrect.
C. Incorrect: This would only be true if the external medium were isotonic (equal salt concentration inside and outside). But since `5% > 1.8%`, the environment is hypertonic, and water must move out. The cell will definitely change size, so it does not remain unchanged.
D. Correct: The salt concentration inside the cell (`1.8%`) is lower than that in the surrounding medium (`5%`). Therefore, the surrounding solution is hypertonic compared to the inside of the cell. In a hypertonic environment, the water potential outside the cell is lower than inside, so water moves out of the cell by osmosis through the semi-permeable membrane. As water leaves, the cell’s volume decreases - it shrinks or crenates (in animal cells).
Question 5
What is osmosis?
A. The movement of water through a membrane from a low to a high solute concentration.
B. The movement of solutes through a membrane from a high to a low water concentration.
C. The movement of water through a membrane from a high to a low solute concentration.
D. The movement of solutes through a membrane from a low to a high water concentration.
Answer: A
A. Correct: Osmosis is defined as the diffusion of free water molecules from a region where they are more concentrated (low solute concentration) to a region where they are less concentrated (high solute concentration) across a partially permeable membrane. In other words, water moves toward where there are more solutes, to dilute the concentrated side and reach equilibrium. Therefore, this option correctly describes the osmosis.
B. incorrect: Osmosis is specifically the movement of water, not solutes. Solutes may move by diffusion or active transport, but not osmosis. Therefore, this description refers to solute movement, not water movement, so it’s incorrect.
C. Incorrect: This reverses the actual direction of osmosis. Water moves toward the region of higher solute concentration, not away from it. So, it’s incorrect because it describes the opposite direction of water flow.
D. Incorrect: This describes solute movement, not water movement. Osmosis does not involve solute transport - only water molecules move. Also, solutes generally move from high to low concentration by diffusion, not the other way around. Hence, this statement is incorrect both in process and direction.
Question 6
Two plant cells are shown as they appear in different solutions X and Y.

What happens to water and pressure potential inside the cell if it is moved from solution X to solution Y? 
Answer: B
A. Incorrect: Water potential does change - it decreases because water leaves the cell. Pressure potential decreases correctly, but since water potential also decreases, this option is incomplete and incorrect.
B. Correct: The cell in solution X appears turgid, meaning it is in a hypotonic solution (external solution has lower solute concentration than inside the cell). The cell solution Y appears plasmolysed, meaning it is in a hypertonic solution (external solution has higher solute concentration than inside the cell). When the cell moves from a hypotonic (solution X) to a hypertonic environment (solution Y), water leaves the cell by osmosis, causing loss of turgor pressure and decrease in both water and pressure potentials. The pressure potential also decreases, because turgor pressure is lost as the vacuole shrinks and the membrane pulls away from the wall.
C. Incorrect: If water potential stayed constant, there would be no net movement of water, but we clearly see plasmolysis (water loss). Also, pressure potential cannot increase when water leaves the cell - it actually drops to zero in plasmolysed cells.
D. Incorrect: The cell is losing water, not gaining it, so water potential decreases, not increases. Similarly, pressure potential decreases as the cell becomes flaccid. So, both statements are opposite of what actually happens.
Question 7
Which process(es) occur(s) by osmosis?
I. Uptake of water by cells in the wall of the intestine
II. Loss of water from a plant cell in a hypertonic environment
III. Evaporation of water from sweat on the skin surface
A. I only
B. I and II only
C. II and III only
D. I, II and III
Answer: B
A. Incorrect: This option says only statement I (uptake of water by intestinal cells) occurs by osmosis. It ignores statement II, which also describes osmosis. In a hypertonic environment, a plant cell loses water through its partially permeable membrane, which is the very definition of osmosis. Therefore, Option A is incorrect because it misses one more correct osmotic process (II).
B. Correct: Osmosis is defined as the diffusion of free water molecules from a region where they are more concentrated (low solute concentration) to a region where they are less concentrated (high solute concentration) across a partially permeable membrane. In the small intestine, water moves from the intestinal lumen (where water concentration is higher) into the cells lining the intestinal wall (where solute concentration is higher). This movement occurs through a selectively permeable membrane. In a hypertonic solution, the surrounding solution has a lower water potential (more solutes) than inside the plant cell. Water therefore moves out of the plant cell across the partially permeable cell membrane by osmosis. As a result, the cell loses turgor and becomes flaccid or plasmolysed. So, both (I) and (II) involve water movement through a selectively permeable membrane due to differences in water potential. However, the statement III involves evaporation, which is a physical process, not osmosis.
C. Incorrect: This option includes evaporation of water from sweat (III). Evaporation is not osmosis. Water changes from liquid to vapor, which is a physical process driven by heat energy, not by differences in water potential. Therefore, Option C is incorrect because statement III does not describe osmosis.
D. Incorrect: This option assumes all three processes involve osmosis. But, as mentioned, statement III (evaporation) does not describe osmosis. Thus, Option D is incorrect because it wrongly includes a non-osmotic process (evaporation).
Question 8
The images show samples of red blood cells that were placed in different concentrations of salt solutions.

Which process explains the observations shown in the images?
A. Active transport
B.Exocytosis
C. Facilitated diffusion
D. Osmosis
Answer: D
A. Incorrect: Active transport requires energy (ATP) and carrier proteins to move substances against their concentration gradient. In this case, water movement is passive and depends on concentration differences, not ATP. Therefore, active transport does not explain the observed changes.
B. Incorrect: Exocytosis is the process of vesicles fusing with the plasma membrane to release substances (like hormones or waste) from the cell. It does not involve water movement or changes in cell size. The red blood cells’ shrinking or bursting is due to osmotic water movement, not vesicle release. So, exocytosis is irrelevant here.
C. Incorrect: Facilitated diffusion involves specific membrane proteins that allow solutes (e.g., ions, glucose) to move down their concentration gradient. It does not involve water molecules, which move through the membrane via osmosis, not via carrier proteins. So, facilitated diffusion cannot explain the water gain or loss seen in red blood cells.
D. Correct: Osmosis is defined as the diffusion of free water molecules from a region where they are more concentrated (low solute concentration) to a region where they are less concentrated (high solute concentration) across a partially permeable membrane. In original solution, the red blood cells are normal (in an isotonic solution; water moves in and out equally). In Solution 1, the external salt concentration is higher than inside the cell (a hypertonic environment), so water leaves the cell, causing it to lose volume and shrink into a crenated shape. In Solution 2, the salt concentration is similar to that inside the cell (an isotonic environment), so there is no net movement of water, and the cell retains its normal biconcave shape. In Solution 3, the surrounding solution has a lower salt concentration (a hypotonic environment), so water moves into the cell, increasing its internal pressure until the cell swells and bursts (hemolysis). Therefore, this entire process is driven by osmosis, not by active mechanisms or protein-mediated transport.
Question 9
Outline the effects of putting plant tissue in a hypertonic solution. [4]
Any four of the following:
a. hypertonic solution has more solutes/higher solute concentration «than the
tissue/cells/cytoplasm»;
b. water moves out of the cells/tissue by osmosis «into the hypertonic solution»;
c. water moves from lower solute concentration to higher solute concentration / up the solute concentration gradient;
d. pressure inside cell drops or cell no longer turgid or cell becomes flaccid;
e. volume of cytoplasm drops or «plasma» membrane retracts from the cell wall or cell is plasmolysed;
Sample answer:
A hypertonic solution has a higher solute concentration than the cell cytoplasm [1].
Water moves out of the cells by osmosis into the hypertonic solution [1].
Water moves from lower solute concentration (inside cell) to higher solute concentration (outside) [1].
Pressure inside the cell drops and the cell becomes flaccid [1].
The plasma membrane pulls away from the cell wall and the cell becomes plasmolysed [1].
Question 10
Explain the process of osmosis with reference to its effects on plant cells. [7]
Any seven of the following:
a. osmosis is water moving through a partially/semi permeable membrane/cell
membrane/aquaporins;
b. osmosis is a form of simple diffusion or water travels down the (water) concentration gradient or osmosis is passive;
c. the solute concentration determines the direction of net movement of water;
d. plant cells in hypotonic solutions will take in water;
e. they will swell/are turgid/develop turgor pressure (in hypotonic solutions);
f. cell wall prevents the plant cells from bursting due to water pressure (in hypotonic solutions);
g. plant cells in hypertonic solutions will lose water;
h. they will shrink/get smaller/flaccid (in hypertonic solutions);
i. the cell membrane will pull away from the cell wall/plasmolysis (in hypertonic solutions);
j. isotonic solutions are the same concentration as inside the plant cells/cytoplasm/cell sap;
k. plant cells will have no net change (in isotonic solutions)/water moves equally in and out of the cell/dynamic equilibrium;
Sample answer:
Osmosis is the movement of water molecules through a selectively (partially) permeable membrane, such as the cell membrane or aquaporins (water channels in membranes) [1]. Water moves from a region of higher water potential (lower solute concentration) to a region of lower water potential (higher solute concentration) until equilibrium is reached [1]. Osmosis is a passive process, meaning it does not require energy because water moves down its concentration gradient. The solute concentration on either side of the membrane determines the direction of water movement [1].
In a hypotonic solution (where the external solution has a lower solute concentration than the cell sap), water enters the plant cell by osmosis [1]. As water enters, the vacuole swells, pushing the cytoplasm against the cell wall. The cell becomes turgid, developing turgor pressure that supports the plant and keeps it firm [1]. The cell wall prevents the cell from bursting even under this pressure because it is strong and rigid [1].
In a hypertonic solution (where the external solution has a higher solute concentration than inside the cell), water moves out of the plant cell by osmosis [1]. The loss of water causes the vacuole and cytoplasm to shrink, and the cell becomes flaccid [1]. As more water leaves, the cell membrane pulls away from the cell wall, a condition known as plasmolysis [1].
In an isotonic solution, the solute concentration outside the cell is equal to that inside the cell sap, so there is no net movement of water - water molecules move in and out at equal rates [2]. The cell remains in a dynamic equilibrium, neither swelling nor shrinking.
Question 11
Explain how water is moved from roots to leaves in terrestrial plants. [8]
Any eight of the following:
a. water enters roots through the root hairs by osmosis;
b. root hairs provide an extended surface area (for active transport and osmosis);
c. active transport of ions from soil into the roots (enhances osmotic pressure);
d. osmotic pressure moves water into the xylem;
e. water is carried (in a transpiration stream) in the xylem;
f. adhesion of water to the inside of the xylem helps move water up;
g. cohesion of water to itself enhances water movement up the xylem;
h. water diffuses into air spaces (in spongy mesophyll) of leaves;
i. it passes out through the stomata by evaporation/transpiration;
j. evaporation sets up a transpiration pull that keeps the water moving;
k. guard cells control the rate of transpiration pull/evaporation;
l. xylem vessels are tubes with helical rings to enhance water movement/resist low pressure;
Sample answer:
Water is absorbed from the soil into the plant mainly at the root hairs by osmosis: root hair cells have a lower water potential than the surrounding soil so water moves down the water-potential gradient into the cells [2]. Root hairs greatly increase the surface area of the root and so maximise uptake of water and of mineral ions. Minerals are taken up by active transport into root cells (using ATP), which lowers the water potential inside those cells and thus enhances osmotic uptake of water [2]. As water accumulates it moves across the root cortex (via apoplast and symplast pathways) and is forced into the xylem, creating a small root pressure; osmotic gradients help push water into the xylem vessels [1]. From the xylem in roots water is carried upward in a continuous transpiration stream to the leaves [1]. Two physical properties of water are essential for this upward movement: cohesion (water molecules stick to one another by hydrogen bonds) maintains an unbroken column of water, and adhesion (water sticks to xylem walls) helps counter gravity and stabilise the column [2]. In the leaves water diffuses into the air spaces of the spongy mesophyll and evaporates through open stomata [1]; this evaporation produces tension (negative pressure) in the leaf xylem that pulls water up from below - the cohesion-tension (transpiration-pull) mechanism [1]. Guard cells regulate stomatal aperture and thus control the rate of evaporation and the strength of the transpiration pull [1]. Finally, xylem vessels are dead, lignified tubes often reinforced with helical rings, which prevent collapse under the negative pressures generated and allow continuous, efficient water transport from roots to leaves [1].
Question 1
Onion (Allium cepa) epidermis was placed in pure water and observed with a light microscope using high magnification.

What would happen to these cells if they were transferred to a hypertonic solution?
A. Cells would gain mass.
B. Cells would take in water by osmosis and swell.
C. Cells would burst open, releasing their content.
D. Cell membranes would detach from walls at some points.
Question 2
In an experiment on osmosis, red blood cells were immersed in a salt solution for two hours. The micrographs show the appearance of these cells before and after immersion in the salt solution.
before immersion after immersion
What explains the observed changes?
What explains the observed changes?
A. The salt solution was hypertonic and entered the red blood cells.
B. The salt solution was hypotonic and disrupted the membranes of the red blood cells.
C. The salt solution was hypertonic and water moved into it from the red blood cells.
D. The salt solution was hypotonic and mineral salts were lost from the red blood cells.
Question 3
A human organ is being prepared for transplant. In what type of solution must it be bathed?
A. A hypertonic solution
B. A hypotonic solution
C. Pure water containing no solutes
D. A solution with the same osmolarity as the organ tissue
Question 4
The salt concentration inside an animal cell is`1.8`%. The salt concentration in the surrounding medium becomes 5 %. What will be the likely response?
A. The cell will gain water from the medium.
B. The cell will lose salt to the medium.
C. The cell will remain unchanged.
D. The cell will shrink from loss of water.
Question 5
What is osmosis?
A. The movement of water through a membrane from a low to a high solute concentration.
B. The movement of solutes through a membrane from a high to a low water concentration.
C. The movement of water through a membrane from a high to a low solute concentration.
D. The movement of solutes through a membrane from a low to a high water concentration.
Question 6
Two plant cells are shown as they appear in different solutions X and Y.

What happens to water and pressure potential inside the cell if it is moved from solution X to solution Y? 
Question 7
Which process(es) occur(s) by osmosis?
I. Uptake of water by cells in the wall of the intestine
II. Loss of water from a plant cell in a hypertonic environment
III. Evaporation of water from sweat on the skin surface
A. I only
B. I and II only
C. II and III only
D. I, II and III
Question 8
The images show samples of red blood cells that were placed in different concentrations of salt solutions.

Which process explains the observations shown in the images?
A. Active transport
B.Exocytosis
C. Facilitated diffusion
D. Osmosis
Question 9
Outline the effects of putting plant tissue in a hypertonic solution. [4]
Question 10
Explain the process of osmosis with reference to its effects on plant cells. [7]
Question 11
Explain how water is moved from roots to leaves in terrestrial plants. [8]